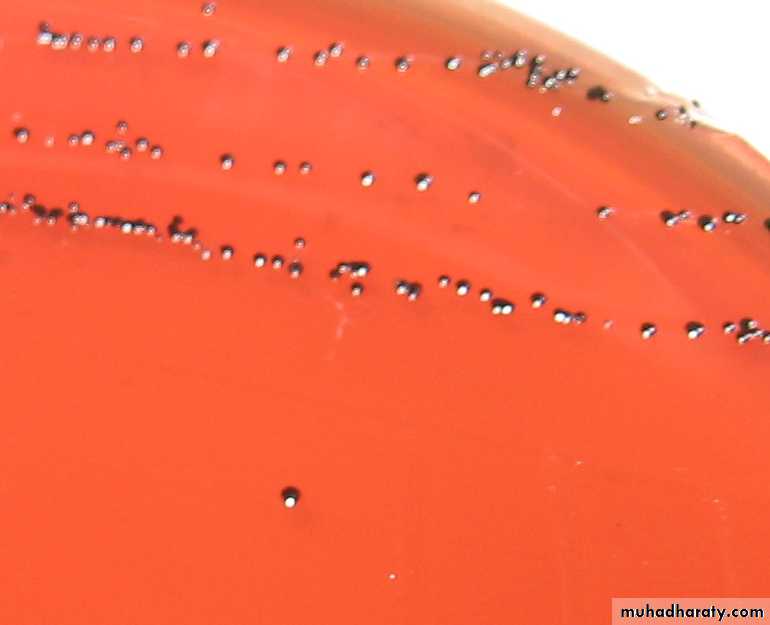

Lab-15
Corynebacterium spp.* General characteristics :-
1-Gram Positive straight or slightly curved bacilli, one or both ends club-shaped, characteristic V and L shaped figures; “Chinese Letters
2-nonmotile
3-Non Capsulated
4-Most spp are Facultative Anaerobes
Cell-wall strecture containing mycolic acid 5-
6- Metachromatic granules at end(stained red) cells stained blue
* Species :-
C. diphtheriae (diphtheria).
Which contain 3 strains :-
C. d. gravis
C. d. mitis
C. d. intermedius
C. hofmannii
C. x erosis
Corynebacterium diphtheria
Laboratory identification
1-Specimen : swab cultures pharynx, nasopharynx, or cutaneous sites)
2-Microscopic morphology:
it is thin , slender rod showing clubbing at one or both ends
it is non motile , non capsulated and non spore forming .
3- the presence of metachromatic granules serve to distinguish
it from diphthroids and the granule consist of polymerized meta phosphate. .
4- The bacilli arranged in pair or groups bacilli form different angles with each others like (V) or (L) and this called Chinese letteres, arrangement and this is due to the incomplete separation of daughter cells after binary fission.
* Culture and Identification :-
1-Staining :-a- gram stain .
b- albert stain .
2- Culture
A-Loffler slope enriched media (horse serum+ nutrient
broth+1%glucose)
2- blood tellurite medium
reduce tellurite to metatic tellurium produce gray/black colonies
and we can distinguish between strain in blood tellurite medium :-
Corynebacterium diphtheriae grivis → 3mm . Radical form . Raised center.
Corynebacterium diphtheriae mitis→ 2.4 mm , Black , smooth margin.
Corynebacterium diphtheriae intermedius→ 1-2 mm , Flat , shiny black
TOXIGENICITY
In vivo: Aculture from Loffler is emulsified in water and 5ml is injected subcutaneously of two guinea pigs one of which has received 1000-2000 units of diphtheria antitoxin intra-peretontialy 2 hours .The unprotected animal should die in 2-3dayes
2-in vitro(Elek’s test)
To determined the toxigenic strain of Corynebacterium diphtheriae.principle:
Toxin production by Corynebacterium diphtheriae by
A precipitation reaction between exotoxin and diphtheria antitoxin
Procedure:
1-place a strip of filter paper saturated with diphtheria Antitoxin on aserum agar plate
2- Streak the test org. across the Plate at right angle to the filter Paper
3- incubate the plate at 35oC for 24 hrs
Result:
Positive test : formation of four radiating lines resulting from the precipitation reaction between exotoxin and diphtheria antitoxin
+ve control(c7B45)
Unknown-ve
* Biochemical test :-Catalase (+)
Oxidase (-)
Gelatinase (-)
Urease (-)
Phosphatase (-)
Table indentification of coryne bacterium species
H2S
Urease
Starch
Sucrose
Glucose
Catalase
M.O
+
-
-
-
-
-
+
-
-
-
-
-
+
+
+
+
+
+
C. d. gravis
C. d. intermedias
C. d. mitis
* Diphtheriods :-
bacilli that morphology resemble diphtheria bacilli and it is not pathogenic , it is found on skin or conjunctiva and oral cavity , and it is opportunistic pathogens.* Morphology :-
It is short 1-5µm with parallel sides and rounded ends, without metachromatic granules.
Actual differentiation can be made out by biochemical testes and virulence test .
Diphtheroids
DiphtheriaG+ , short and thick
Absence or rareGrow on ordinary media
Fermentation of glucose , sucroseUsually non toxic
A- morphology
1- G+ and thin
2- meta chromatic granules are more
B- culture
Grow on enrich media
C- biochemical test
Fermentation of glucose
D- they are toxic